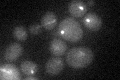
YBL063W
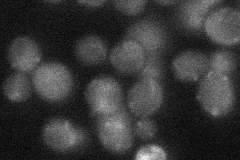
YBL063W
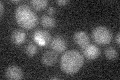
YBL063W

View description
Kinesin-related motor protein required for mitotic spindle assembly, chromosome segregation, and 2 micron plasmid partitioning; functionally redundant with Cin8p for chromosomal but not plasmid functions
Localization:
Intensity:
Fold change:
Significance:
-
C’ GFP library in SD
punctate19.23 -
N' NOP1pr-GFP in SD

punctate47.34 -
N' TEF2pr-mCherry in SD

punctate0 -
N' NATIVEpr-GFP in SD
bud neck24.3719 -
N' TEF2pr-VC and Cyto-VN in SD

#N/A0 -
C’ GFP library in SD+DTT

punctate17.20.89No -
C’ GFP library in SD+H2O2

punctate20.351.05No -
C’ GFP library in Starvation Media
cytosol15.510.8No -
C’ GFP library on the background of Pup2-DaMP

punctate -
C’ GFP library on the background of CCT mutant

punctate23.11711.20174No
